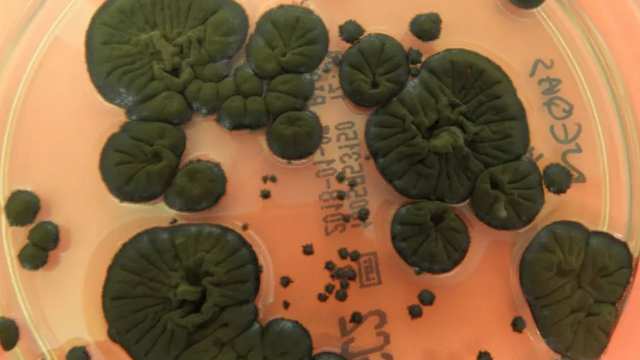
В Чернобыле нашли грибок, который питается радиацией

Северное сияние в Казахстане: учёный объяснил явление

Минувшей ночью североказахстанцы наблюдали удивительное по своей яркости северное сияние. Ночное небо окрасилось в цвета радуги над домами сразу нескольких населенных пунктов региона. В том числе небесную красоту могли наблюдать на окраине Петропавловска. По словам астрофизиков, удивительное явление в регионе еще повторится, пишет Qostanay.TV со ссылкой на BaigeNews.kz.
Природное явление стало заметно североказахстанцам примерно около 11 часов вечера. Сельчанам размытое красками небо было видно гораздо лучше. Горожане же отмечают, что удивительное свечение сложно во всех красках зафиксировать в кадре.
«Было уже поздно. Я возвращался домой, как, выйдя из машины оторопел. В жизни не видел подобное. Разве что на картинках. Не сразу понял, что это северное сияние. Оно ведь непривычно для нас. Кончено, цвета были не такие насыщенные, как мы привыкли видеть на фотографиях. Жена достала телефон, пыталась сделать снимки. Но передать то, что видит глаз, камера не смогла. Сейчас многие говорят о перестройке климата, и что нас впереди ждут глобальные перемены. Быть может, это и есть предвестник перемен», — ответил житель Петропавловска Владимир.
Полярное сияние осталось незамеченным для большинства горожан. На утро они могли наслаждаться только фотографиями, сделанными соседями.
«Это как-то волнительно, наблюдать подобное. Это же частичка космоса, большого мира, до которого нам не достать рукой. Конечно, с научной точки зрения все объяснимо. Но полярное сияние не может не завораживать. Причем мы не видели его еще в полной мере. На нашем небе в основном был изумрудный цвет. Кто-то говорит о преобладании розового», — рассказала горожанка Марина.
Возможность будет
По словам астрофизиков, тем, кто не успел собственными глазами увидеть полярное сияние, представится еще одна возможность. Судя по прогнозу специалистов области, сегодня 6 ноября, магнитная буря должна продолжиться. Но уже завтра явление закончится.
«Это скорее экзотика, чем нечто необычное. Но и чудом, конечно, это не назовёшь. Потому что такие явления раз в несколько лет на севере Казахстана наблюдаются. Если посмотреть на Землю из космоса, то вокруг магнитных полюсов планеты существует такая светящаяся область. Так называемая магнитная каспы, где высыпаются высокоэнергичные частицы. Прежде всего это протоны плотных облаков солнечного ветра, приходящие из области коронарных дыр. А вчера так случилось, что к нам такое облако и пожаловало. Корональная дыра была направлена в сторону Земли. Это бывает чаще всего либо весной, либо осенью. Бывает иногда и летом из области солнечных вспышек также долетают эти плазменные облака. Свечение возникает из-за того, что эти частицы взаимодействуют с тем самым кислородом, которым мы дышим. И с азотом. Кислородной свечение обыкновенно красного и зелёного цвета. Азот вызывает свечение синеватого цвета», — пояснил профессор университета, астроном Андрей Солодовник.
Он объяснил, почему сельчане могли насладиться полярным сиянием в большей степени.
«Наши города сейчас сильно освещены. Ночью включен свет на домах, уличное освещение. Это, конечно же, нужно. Но когда освещаются высокие здания, звёзд на небе трудно увидеть. Что уже говорить о полярном сиянии. В этом отношении сельчане находится в гораздо выгодных условиях, и могут это явление наблюдать во всей красе. Конечно, это будет видно в северной части горизонта. Но если энергия высыпания частиц очень велика, то может распространиться по всему небу. Как-то в эпоху начала цифровой фотографии я, пробуя камеру, наблюдал такое свечение. Оно перемещалось по небу такого желтоватого цвета и практически через зенит прошло. Другая фотография у нас относилась к эпохе наблюдения серебристых облаков сезона 2016 года. Тогда наш магистрат Николай Васильев сделал красивейший снимок серебристых облаков и полярных сияний, которые наблюдались в северной части неба», — вспомнил собеседник.
Удивляться не стоит
Если говорит о полярном сиянии на территории Северного Казахстана, то явлению особо удивляться не стоит. Однако если речь идет о юге страны, то, по словам астрофизика, это должно впечатлить.
«Сегодня я с удивлением узнал, что полярное сияние наблюдалось и на юге Казахстана. Но это уже подлинно сенсация. Надо сказать, что геомагнитная буря, которая вызвала его, не отличается какими-то экстремальными параметрами. По своей интенсивности она относится к средним или умеренным. Видимо так сложилось, что именно в наших краях, широтах и долготах эти сияния стали заметными. Вполне возможно, что и в других областях Казахстана и других стран, расположенных в умеренных широтах, также эти сияния в этот день отмечались», — отметил Андрей Солодовник.
Астофизик напоминает, что влияние магнитных бурь на Солнце имеет и тяжелые последствия. По его словам, в шестидесятые годы прошлого века экстремальные солнечные бури вызывали появление электрических токов в сетях.
«Появление было такого огромного масштаба, что эти электрические сети выходили из строя. Так, в Америке и Канаде в 1968 году, если память мне не изменяет, последствия бури вышли на государственный масштаб. На пару суток многие регионы остались вообще без электричества, электрические и трансформаторные подстанции сгорели. В наш век магнитные бури влияют и на качество интернета, телефонной связи. На всё, что откликается на изменение магнитного поля нашей планеты. Что же касается индивидуального влияния явления на человека, то оно общеизвестно. В мире существует интернациональная служба Солнца. Учёные постоянно обмениваются информацией о состоянии нашего светила. Таким образом оказывается возможным предсказать возникновения геофизически неблагоприятных дней, когда мы себя плохо чувствуем, хватаемся за сердце или голову. В общем-то, мы все действительно находимся в паутине магнитного поля Земли и эти плазменные облака деформируют магнитное поле. Возникают пульсации. От того и самочувствие меняется», — уточнил собеседник.